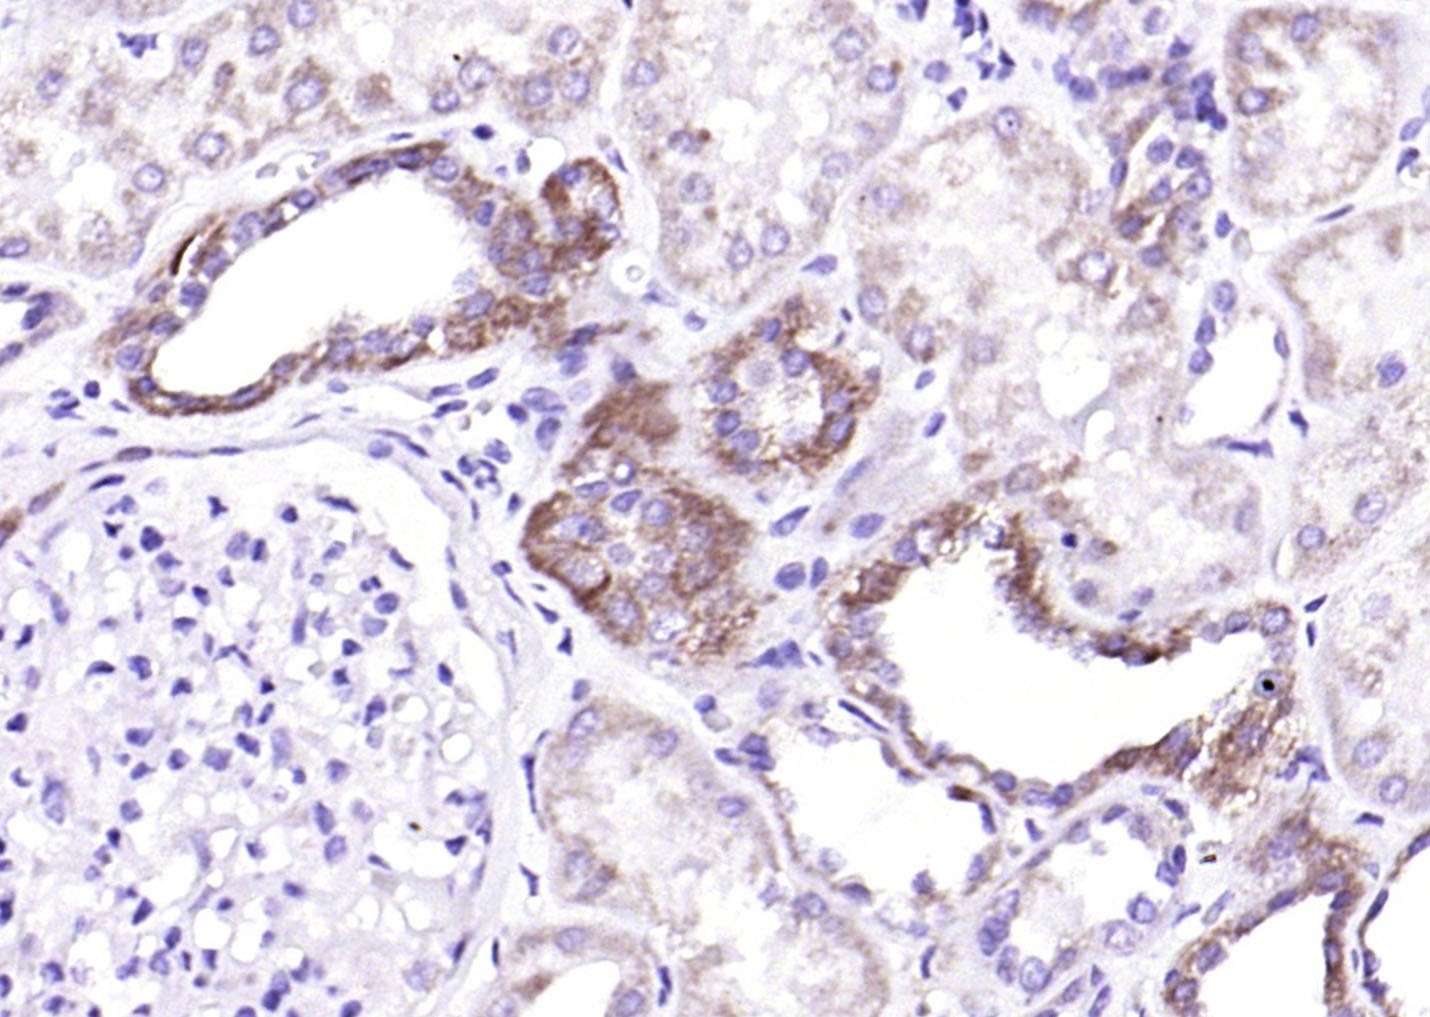
产品细节图片2

相关产品推荐更多 >
万千商家帮你免费找货
0 人在求购买到急需产品
- 详细信息
- 文献和实验
- 技术资料
- 应用范围:
产品信息以Bioss网站为准
- 规格:
50ul/100ul/200ul
| 规格: | 50ul | 产品价格: | ¥1180.0 |
|---|---|---|---|
| 规格: | 100ul | 产品价格: | ¥1980.0 |
| 规格: | 200ul | 产品价格: | ¥2800.0 |
| 产品编号 | bs-0449R |
| 英文名称 | TSLP Rabbit pAb |
| 中文名称 | 胸腺基质淋巴细胞生成素-1抗体 |
| 英文别名 | Thymic stromal lymphopoietin; Thymic stromal lymphopoietin isoform 1; Thymic stromal lymphopoietin protein TSLP; TSLP protein; TSLP_HUMAN. |
| 产品应用 | WB=1:500-2000, IHC-P=1:100-500, IHC-F=1:100-500, IF=1:100-500 Not yet tested in other applications. |
| 交叉反应 | Human |
| 抗体来源 | Rabbit |
| 免疫原 | KLH conjugated synthetic peptide derived from human TSP-1 |
| 亚型 | IgG |
| 性状 | Liquid |
| 纯化方法 | affinity purified by Protein A |
| 克隆类型 | Polyclonal |
| 理论分子量 | 15 kDa |
| 浓度 | 1mg/ml |
| 储存液 | 0.01M TBS (pH7.4) with 1% BSA, 0.02% Proclin300 and 50% Glycerol. |
| 研究领域 | Immunology > Innate Immunity > Cytokines |
| 亚基 | Interacts with a receptor composed of CRLF2 and IL7R. |
| 亚细胞定位 | Secreted. |
| 组织特异性 | Expressed in a number of tissues including heart, liver and prostate. |
| 功能 | Cytokine that induces the release of T-cell-attracting chemokines from monocytes and, in particular, enhances the maturation of CD11c(+) dendritic cells. Can induce allergic inflammation by directly activating mast cells. |
| 保存条件 | Shipped at 4℃. Store at -20℃ for one year. Avoid repeated freeze/thaw cycles. |
| 注意事项 | This product as supplied is intended for research use only, not for use in human, therapeutic or diagnostic applications. |
| 背景资料 | Thymic stromal lymphopoietin (TSLP) is a novel cytokine that was found to promote the development of murine B cells in vitro. This protein, which is expressed in a number of tissues including heart, liver and prostate, prevented apoptosis and stimulated growth of the human acute myeloid leukemia (AML)-derived cell line MUTZ-3. Anti-interleukin (IL)-7 receptor antibodies (Abs) neutralized this effect indicating that TSLP binds to at least part of the IL-7 receptor complex. TSLP induced phosphorylation of signal transducer and activator of transcription (STAT)-5. |
| 应用 | 推荐稀释比例 |
| {WB} | {1:500-2000} |
| {IHC-P} | {1:100-500} |
| {IHC-F} | {1:100-500} |
| {IF} | {1:100-500} |

Antigen retrieval: citrate buffer ( 0.01M, pH 6.0 ), Boiling bathing for 15min; Block endogenous peroxidase by 3% Hydrogen peroxide for 30min; Blocking buffer (normal goat serum,C-0005) at 37℃ for 20 min;
Incubation: Anti-TSLP Polyclonal Antibody, Unconjugated(bs-0449R) 1:500, overnight at 4°C, followed by conjugation to the secondary antibody(SP-0023) and DAB(C-0010) staining
风险提示:丁香通仅作为第三方平台,为商家信息发布提供平台空间。用户咨询产品时请注意保护个人信息及财产安全,合理判断,谨慎选购商品,商家和用户对交易行为负责。对于医疗器械类产品,请先查证核实企业经营资质和医疗器械产品注册证情况。
文献和实验[IF={{ 6.8 }}] {Jana Zeitvogel. et al. Short-form thymic stromal lymphopoietin (sfTSLP) restricts herpes simplex virus infection of human primary keratinocytes. J MED VIROL. 2024 Sep;96(9):e29865} {WB} {Human}
[IF={{ 5.34 }}] {Dian-Dong Hou. et al. Therapeutic effects of myricetin on atopic dermatitis in vivo and in vitro. PHYTOMEDICINE. 2022 Jul;102:154200} {IHC} {Mouse}
[IF={{ 3.483 }}] {Shen Z et al. Insights into Roseburia intestinalis which alleviates experimental colitis pathology by inducing anti-inflammatory responses. J Gastroenterol Hepatol. 2018 Oct;33(10):1751-1760.} {IHC} {Mouse}
[IF={{ 2.493 }}] {Min-jie Gong. et al. Melatonin reduces IL-33 and TSLP expression in human nasal epithelial cells by scavenging ROS directly. IMMUN INFLAMM DIS. 2023 Feb;11(2):e788} {WB} {Human}
[IF={{ 0.67 }}] {Sakitani, Eri, et al. "Increased Expression of Thymic Stromal Lymphopoietin and Its Receptor in Kimuras Disease." ORL 77.1 (2015): 44-54.} {Other} {=""}
= NAL), appears to form upon oxidative cyclization of the nonfluorescent 2:1 lysine-HNE Michael adduct-Schiff base cross-link (Scheme 1). Polyclonal antibody (PAb) to the NAL-HNE fluorophore was raised in rabbit and found to be highly specific
GE Healthcare Benzamidine Sepharose™ 6B is p-aminobenzamidine covalently attached to Sepharose 6B by the epoxy coupling method. p-Aminobenzamidine (PAB), is a synthetic inhibitor of trypsin-like serine protease. Trypsin and trypsin
Nucleic Acid Programmable Protein Arrays: Versatile Tools for Array‐Based Functional Protein Studies
.g., Sigma) 50 mg/ml bis‐sulfosuccinimdylsuberate (BS3 ;Pierce, cat. no. PI 21580) in dimethylsulfoxide (DMSO) 5 mg/ml
技术资料暂无技术资料 索取技术资料









